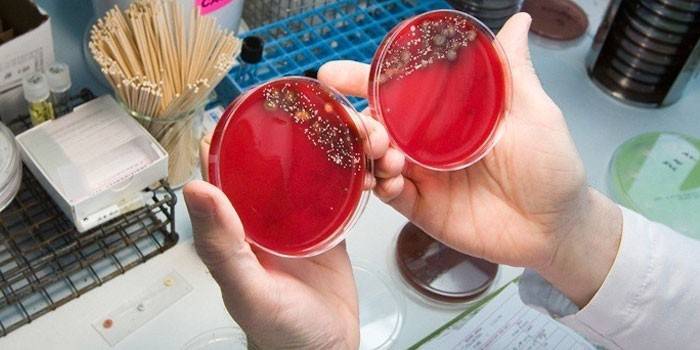

Иногда человек становится носителем инфекции, о существовании которой в организме не подозревает. Одной из таких скрытых угроз является уреаплазма, которая формально представляет вредоносные бактерии, но по свойствам имеет определенные сходства с вирусами. Существует несколько разновидностей этого паразитирующего одноклеточного микроорганизма. Для постановки окончательного диагноза необходимо провести бакпосев на уреаплазму. Направление дает лечащей врач строго по медицинским показаниям.
Что такое уреаплазма
По сути, это примитивный патогенный микроорганизм, носителями которого в большинстве своем (порядком 60%) становятся женщины. Самыми опасными видами для здоровья человека являются Ureaplasma parvum и Ureaplasma urealiticum, которые базируются в тканях мочеполовой, мочевыводящей и бронхолегочной системы. Имея определенные сходства с бактериями и вирусами, уреаплазмы длительное время остаются незамеченными, а выявляются случайно, например, при прохождении планового медосмотра. Болезнь, которую провоцируют эти микробы, называется уреаплазмозом.
Причины быстрого развития уреаплазмы
Проникая в организм человека, патогенная флора при отсутствии патогенных факторов никак себя не проявляет, поэтому болезнь протекает в так называемой «спящей форме». При создании благоприятных условий микробы начинают продуктивно размножаться, провоцируя острую симптоматику уреаплазмоза. Патогенные факторы для развития указанного заболевания таковы:
- ослабленный длительной болезнью иммунитет;
- продолжительный курс антибиотиков;
- половые инфекции;
- частая смена сексуальных партнеров;
- анальный половой акт;
- нарушение микрофлоры влагалища (для женщин);
- наличие оральных ласок в сексе;
- нарушение правил личной гигиены;
- посещение бань, саун, бассейнов;
- ранняя половая жизнь.
Симптомы инфекции уреаплазма в организме
Лечащий врач назначает сдать анализ на уреаплазму у женщин и мужчин при появлении характерных для инфекционного заболевания симптомов, интенсивность которых при отсутствии своевременного лечения только усиливается. Признак уреаплазмоза таковы:
- жжение в процессе мочеиспускания;
- гиперемия и повышенная отечность уретры;
- частое, затрудненное мочеиспускание;
- выделение из влагалища слизистых примесей с кислым запахом;
- тянущая боль нижней части живота;
- нарушенный менструальный цикл;
- болевой синдром заднего прохода;
- дискомфорт и боль при половом контакте;
- зуд слизистой влагалища;
- рези в нижней части живота.
Такая неприятная симптоматика свойственна острой стадии заболевания. При хроническом уреаплазмозе представленные выше симптомы выражены слабо, но пациент пребывает в состоянии постоянного дискомфорта. Проявление недуга усиливается при половом контакте или в стадии рецидива, например, на фоне ослабления иммунного ответа организма. Чтобы четко определить преобладающую клиническую картину, требуется выполнить мазок на уреаплазму у женщин или мужчин. Микроб опасен для внутриутробного развития плода.
Методы анализа на уреаплазму
Забор биологического материала осуществляется в амбулаторных условиях, а исследуется потом в лаборатории. Для постановки окончательного диагноза врачи рекомендуют пациенту пройти такой комплекс диагностических мероприятий:
- бактериологический посев (культуральный метод);
- полимеразная цепная реакция (ПЦР);
- иммуноферментный анализ (ИФА).
Если выполнить бакпосев, можно не только определить факт присутствия патогенной флоры, но и выявить ее численность в организме, реакцию вредоносных микроорганизмов на антибиотики. Это хорошая возможность индивидуально определить схему интенсивной терапии, установить оптимальную дозировку антибактериальных средств, необходимых для истребления микробов.
Культуральный посев
Такой бактериологический метод исследования отличается высокой точностью, выявляет инфекцию даже при бессимптомном течении патологического процесса. Его суть заключается в помещении биоматериала в специальную питательную среду и дальнейшее наблюдение за ним на протяжении 4-8 дней. Если в мазке имеются бактерии, они начинают стремительное размножение, которое как раз и фиксирует знающий специалист.
Забор биологического материала берется из влагалища, канала уретры и шейки матки. Для лабораторного исследования можно взять мочу, но результат проведения такой диагностики считается менее информативным. Из преимуществ культурального посева врачи выделяют доступность и высокую точность методики. Недостаток – длительное ожидание достоверного результата.
Полимеразная цепная реакция
Чувствительность данного метода составляет 98%, поэтому результаты полимеразной цепной реакции (в дальнейшем ПЦР) можно считать максимально достоверными. Допустимый биологический материал – кровь, моча, жидкость из влагалища, уретры. Время проведения процедуры – от 4 до 24 часов в зависимости от выбранных для анализа реактивов. Основная задача исследования – выявление генетического кода возбудителя инфекции.
В ходе лабораторного исследования специалист занимается поиском генов, характерных для уреаплазмы. Среди преимуществ метода ПЦР является быстрота исследования, высокая точность и достоверность результатов. Главный недостаток таков: не исключено получение ложноположительного или ложноотрицательного ответа. Это объясняется тем, что анализ лишь констатирует факт присутствия микробов, а ее форму (активную или неактивную) таким способом определить не получится.
Иммуноферментный анализ
В этом случае биологическим материалом для дальнейшего лабораторного исследования методом ИФА является кровь. После забора ее помещают на специальную полоску с антигенами возбудителя болезни. Таким способом можно определить наличие антител и поставить пациенту окончательный диагноз, поскольку для каждой разновидности инфекции вырабатываются особые иммунные белки.
Проводится такая проба в лаборатории, исследование длится не более 24 часов, в чем главное преимущество иммуноферментного анализа. Недостатком ИФА является неточность полученных результатов, поскольку микробы даже при их наличии не всегда обнаруживаются. При таких сбоях патогенная инфекция так и остается не выявленной, а клиническая картина заболевания заметно осложняется.
Рекомендации перед сдачей анализа
Подготовительные мероприятия зависят от вида биологического материала, половой принадлежности пациента. Например, кровь берут утром натощак, выполняется забор утренней порции мочи. Анализ на уреаплазму у мужчин проводят путем взятия соскоба из уретры (пациент за 2 часа до забора не должен мочиться). Процедура неприятная, но полученный результат максимально достоверный. Посев на уреаплазму парвум и другие виды инфекции не проводится при менструации, поскольку биологический материал с примесями крови является неинформативным. Другие рекомендации представлены ниже:
- Накануне вечером перед выполнением анализа на уреаплазму требуется провести гигиену половых органов. Гели, мази в это время лучше не использовать, только гипоаллергенные антисептики, а лучше вообще подмываться без использования мыла.
- За несколько дней до лабораторного исследования рекомендуется отказаться от антибиотиков, временно приостановить курс антибактериальной или противовирусной терапии. В противном случае информативность анализа на уреаплазму в разы снижается.
- Перед проведением лабораторного исследования рекомендуется не заниматься сексом. Если половой контакт все же намечается, разрешено использовать только барьерные контрацептивы (презервативы).
- Если предстоит сдавать анализ на уреаплазму, за несколько дней требуется отказаться от употребления алкоголя в любом виде. Другие вредные привычки пациента тоже попадают под запрет.
- Накануне вечером желательно воздержаться от принятия горячих ванн, не выполнять спринцевание. С другими домашними процедурами с целью снизить интенсивность симптоматики тоже желательно повременить.
- Если пациенту назначено выполнить анализ на уреаплазму, а накануне он проходил антибактериальное лечение, об этом в индивидуальном порядке требуется сообщить компетентному специалисту.
- Оптимальным периодом, чтобы взять мазок на уреаплазму у женщин, является середина менструального цикла. В целом, указанный временной интервал может несколько варьироваться.
- Дополнительно может быть назначен серологический анализ, но его точность и достоверность во многих клинических случаях попадает под большое сомнение. Посев на уреаплазму уреалитикум более информативный, но результат зависит от четкости подготовительных мероприятий и правильного забора биологического материала.
Расшифровка анализов на уреаплазму
По показателям нормы можно определить наличие или отсутствие указанного заболевания. После расшифровки мазок на уреаплазму у мужчин и женщин помогает точно дифференцировать уреаплазмоз, исключить развитие простатита (у мужчин), хламидиоза, гонореи, других инфекций, которые передаются преимущественно половым путем. В зависимости от метода лабораторного исследования, расшифровка имеет такое содержание:
- Для метода ИФА в заключении обозначен титр (показатель антигена). В здоровом организме напротив него ставится отметка «норма».
- Для метода ПЦР допустимый показатель уреаплазм соответствует 104 КОЕ на 1 мл. Большее значение титра свидетельствует о патологии.
- Для бактериологического метода в заключении указывается не только концентрация патогенной флоры, но и конкретный тип возбудителя с рекомендациями относительно антибактериальной терапии.
Уреаплазмоз является заболеванием, которое вызывает воспалительный процесс в мочеполовой системе. Оно не считается венерическим, хотя и передается половым путем. При возникновении болей во время мочеиспускания, появлении непонятных выделений, а также если семья долгое время пытается завести ребенка, но у них не получается, врач назначает анализ на уреаплазму. Исследование может производиться различными методами, которые имеют свои плюсы и минусы.
В каких случаях назначается и когда необходим повторный анализ
Когда необходимо сдавать анализ, признаки у представительниц прекрасного пола:
- тянущие боли внизу живота;
- специфические выделения из половых путей (слизистые или слизисто-гнойные);
- покраснение в области уретры;
- неприятные ощущения при мочеиспускании (зуд и жжение);
- кровянистые мажущие выделения в периодах между менструациями;
- болевые ощущения во время или после полового акта;
- отечность влагалища.
Если посмотреть, как выглядит уреаплазмоз у мужчин на фото, то можно заметить внешние симптомы. Возникают они в виде покраснения и отечности уретры. Заболевание проявляется у мужчин следующим образом:
- жжение, зуд в уретре и во время мочеиспускания;
- скудные, прозрачные выделения из уретры (слизистые или слизисто-гнойные);
- частые позывы сходить в туалет;
- болезненные ощущения, отдающие в прямую кишку.
Также, анализ на уреаплазму назначается в следующих ситуациях:
- при планировании беременности;
- наступление беременности;
- признаки воспалительного процесса у мужчин в мочеиспускательном канале и простате;
- симптомы и проявления воспаления влагалища, шейки матки, уретры у женщин;
- наличие выкидышей в анамнезе;
- подозрение на бесплодие;
- когда человек является донором спермы.
Причиной для исследований может быть уреаплазмоз после лечения (для предотвращения рецидивов назначается повторный анализ). Вторичное заболевание может возникнуть в результате ослабления защитных сил организма.
Иммунная система может дать сбой под воздействием следующих факторов:

- частые переохлаждения, перегревы, пребывание на сквозняках;
- сопутствующие патологические состояния;
- употребление алкоголя, наркотиков, курение;
- нездоровое питание;
- постоянные стрессы, переживания;
- хронические депрессии;
- частое переутомление, недосып;
- плохая экологическая обстановка.
Также обследование необходимо в первые дни жизни новорожденного, если инфекция была во время беременности у матери. В этом случае патогенный микроорганизм может перейти к младенцу по родовым путям во время появления на свет. Инфицирование малыша может вызвать для него тяжелые последствия.
Виды анализов
Обследование на уреаплазмоз может производиться следующими методами диагностики:
- ПЦР (называется полимеразной цепной реакцией). При таком диагностическом мероприятии берется соскоб на наличие инфекции.
- ИФА (иммуноферментный анализ). Такой вид исследования подразумевает под собой забор крови для изучения.
- Анализ на бактериальный посев (культуральный метод).
Проверить также необходимо состав мочи. Сдавать анализы на наличие патологического состояния обязательно при возникновении подозрений на него. Таким образом получится своевременно выявить инфекцию и начать необходимое лечение. Чем раньше будет начата терапия, тем легче будет избавиться от воспалительного процесса без возникновения осложнений. Методы обследования на наличие патогенных микроорганизмов одинаковы для пациентов любой половой принадлежности и возрастной категории.
Для данного обследования берется соскоб (мазок) со слизистых оболочек мочеиспускательного канала или половых органов. Также, может быть использован другой биологический материал для изучения его состава под микроскопом в лабораторных условиях.
ПЦР ureplasma spp позволяет не только обнаружить патогенные микроорганизмы, но и определить их количественный показатель. Полимеразная (полимерно) цепная реакция выявляет даже самые опасные типы заболевания. Диагностическое исследование способно обнаружить, выявить количество и определить место локализации инфекции в 99% случаев.
Иммуноферментный анализ
Такой анализ крови на патоген уреаплазмы применяется редко. Это связано с тем, что он предоставляет меньше информации, чем полимеразная цепная реакция или бактериальный посев. Такой метод, как правило, применяется в качестве дополнительного обследования для подтверждения диагноза.
ИФА (иммуноферментный анализ) определяет иммуноглобулины в кровяной жидкости. Так как данные элементы принадлежат к различным группам, каждый вид в анализе указывается по отдельности. Наличие антител типа М говорит о начале воспалительного процесса и включении защитных сил в организме. Элементы из группы G свидетельствуют о продолжительном течении заболевания или об излечении от него (так как этот тип иммуноглобулинов наблюдается в крови и после проведенной терапии).
Анализ мочи
Анализ мочи берется в утреннее время. Урина для обследования должна находиться в организме не более 6 часов. Перед забором материала необходимо тщательно следить за интимной гигиеной.
Биологический материал (урину) собирают в специальный стерильный контейнер. В этот же день он относится в лабораторию для исследования. Если в моче присутствуют патогенные микроорганизмы, они начинают образовывать колонии. Если вы проходите курс терапии медикаментами и не могли на время отменить лечение, сообщите об этом лаборанту. Это поможет исключить ошибки в результатах исследования.
При сдаче мочи на исследование в лабораторию могут быть также выявлены сопутствующие патологические состояния. Для подтверждения их наличия назначаются дополнительные диагностические мероприятия. Только после этого может быть поставлен точный диагноз и назначено эффективное лечение.
Бакпосев на уреаплазму
Уреаплазма в мазке может быть обнаружена, если назначается культуральное обследование. Бакпосев на микроорганизм дает количественное определение патогена уреаплазмы. Для этого биологический материал помещается в специальную питательную среду выращивания. Под микроскопом изучается количество бактерий на 1 мл сданной жидкости. Также проводится исследование на чувствительность к антибиотикам различной группы.
Посев на уреаплазму с определением чувствительности к антибиотикам берется со слизистых оболочек мочеполовых путей. Мазок у женщин на инфекцию производится с внутренних стенок влагалища. Бакпосев на патоген у мужчин собирается с уретры. При этом изучают также эякулят.
Бактериальный посев на уреаплазму, парвум, spp и количественный анализ (ПЦР) активно применяются для выявления в организме патогенных микроорганизмов. Оба метода диагностики имеют свои плюсы в той или иной ситуации. Мазок на ПЦР (количественное определение) помогает выявить вид Mycoplasma genitalium. Мазок у женщин и мужчин культуральным методом рекомендуется для выявления типов Mycoplasma hominis и Ureaplasma spp.
Как подготовиться
Подготовка к анализу мазка ПЦР производится следующим образом:
- за два дня до сдачи анализа необходимо приостановить употребление антибиотиков;
- за два дня не использовать средств местного назначения и контрацептивов;
- подмыться необходимо с вечера без использования средств для гигиены, утром процедуры проводить нельзя;
- за два дня до анализа не вступать в половой контакт;
- перед сдачей анализа не ходить в туалет три часа;
- нежелательно делать мазок после кольпоскопических проб.
Подготовка к анализу ИФА:
- Кровь нужно сдавать на голодный желудок. Последний прием пищи должен быть как минимум за двенадцать часов до исследования.
- Как минимум за тридцать минут до сдачи анализа нельзя курить.
- За два-три дня до забора крови не рекомендуется употреблять спиртные напитки.
- Запрещен прием некоторых медикаментов. Если вы проходите какой-то курс терапии препаратами, сообщите об этом врачу.
Подготовительные мероприятия к бакпосеву:
- у женщин материал берется не ранее двух-трех дней после окончания менструации;
- за день до сдачи анализа нельзя принимать антибактериальные препараты;
- за два дня до бакпосева воздержитесь от полового контакта;
- за день до анализа не используйте местные препараты и контрацептивы;
- за семь-десять дней прекращается лечение вагинальными средствами, антибиотиками;
- подмываться можно только вечером без мыла, утром это делать нельзя;
- воздержаться от похода в туалет за два-три часа до сдачи анализа.

Перед сдачей мочи необходимо за день перестать есть жареное, соленое, сладкое. А также пить алкоголь и кофе. Перед сбором урины нужно хорошо подмыться без мыла. Если вы принимаете какие-то лекарственные препараты, сообщите перед забором мочи об этом специалисту. Сбор урины необходимо производить в стерильную, сухую емкость. Специальный контейнер можно приобрести в любой аптечной сети. Мочу нужно собирать в количестве 20-30 мл и хранить в прохладном месте до передачи в лабораторию.
Как берут анализ на уреаплазму у мужчин
Мужчины сдают для выявления патогенного микроорганизма соскоб с поверхности уретры, мочу, эякулят. В этом биологическом материале наблюдается наибольшее скопление инфекции. Как берут анализ на уреаплазму (соскоб) у мужчин:
- Перед тем как сдается анализ, нельзя ходить в туалет два-три часа. Это необходимо, чтобы на поверхности слизистой оболочки накопилось как можно больше патогена.
- Биологический материал для полимеразной цепной реакции и на бакпосев берется при помощи тонкого зонда со щеточкой на конце.
Сдать анализ (ПЦР, бакпосев) на уреаплазму мужчине необходимо сразу же при возникновении подозрений на воспалительный процесс. Это, конечно, довольно неприятная процедура, но при правильных действиях медицинского работника болезненных ощущений не вызывает.
Как берется анализ на уреаплазму у женщин
Анализ на уреаплазмоз, микоплазму у женщин берется при помощи мазка из уретры, влагалища, шейки матки. Забор биоматериала назначают в зависимости от сопутствующих заболеваний, цели проведения исследования.
Анализ на уреаплазму у женщин при подозрении на уретрит, дисбиоз, вагинит берется со стенок влагалища. При наличии других сопутствующих заболеваний мочеполовой системы, мазок снимается с цервикального канала шейки матки. Как сдавать анализ:
- Чтобы взять мазок, специалист сажает женщину на гинекологическое кресло.
- При помощи специального зонда-щеточки снимается соскоб.
- Гинеколог пишет направление и отправляет биоматериал на исследование в лабораторию.
Как правило, процедура не доставляет болезненных ощущений. Может возникнуть лишь небольшой дискомфорт, который быстро проходит.

Расшифровка результатов
Расшифровка анализа на патоген уреаплазму производится исходя из показателей нормы. Если даже в биоматериале уреаплазма 10 обнаружена, это вовсе не свидетельствует о том, что человек болен и ему необходимо лечение. Не пытайтесь самостоятельно диагностировать себе патологическое состояние.
При ИФА на бланке с результатом анализа будет графа «антитела в пробе». Когда уреаплазма в биоматериале не представляет опасности, рядом с этой графой должно стоять слово «норма». Показатели в цифрах уреаплазмы могут в разных медицинских учреждениях различаться. Поэтому расшифровка анализа производится по слову «норма». Бывает, что анализ на ureaplasma urealyticum parvum или на другие виды бывает сомнительным. В этом случае назначаются дополнительные исследования для выявления возбудителей инфекции.
Нормальное значение, если анализ берется культуральным методом или при помощи ПЦР — не более 10 в 4 степени КОЕ на 1 мл. При таких исследованиях если уреаплазма 10 больше 4, 5 степени, это свидетельствует об активности патогенного микроорганизма. В этом случае назначается необходимое лечение.
Показатели в норме
Норма уреаплазмы в мазке у мужчин и женщин одинаковая. Референсные значения «не обнаружено» говорят о том, что инфекции в организме нет.
В анализах ПЦР показатели (титры) 10*3 свидетельствуют о том, что количество патогенов в биоматериале в норме. То есть уреаплазма 10 до 3 степени означает, что микроорганизмы присутствуют, но в такой концентрации не способны вызвать заболевание. Посев на уреаплазму нормальные показатели — в концентрации менее 10 в 4 степени.
У женщин норма мазка предельная такая же, как и у мужчин. Максимальная норма при методе ПЦР и при бакпосеве одинаковая. Уреалитикум, специес, парвум у женщин, мужчин в анализе должен иметь уровень 10*4-10*5. При таком допустимом значении могут быть назначены дополнительные обследования.
Расшифровывать самостоятельно результаты анализов и ставить себе диагноз не стоит. Какое считается нормой значение уреаплазмы, может определить только высококвалифицированный специалист. Показатели могут меняться под воздействием различных факторов.
Отклонения от нормы
Показатель уреаплазма 10 (ДНК ureaplazma urealyticum и другие виды) в 5 степени считается гранью между нормой и ее отклонением. В этом случае специалист принимает решение о дальнейших действиях. Может быть назначено дополнительное обследование или лечение.
Когда в организме присутствует уреаплазма парвум, igg или другие виды и норма отклонена от необходимых показателей, назначается, как правило, терапия поддерживающими препаратами для укрепления иммунной системы. Чем сильнее защитные силы организма, тем ниже риск активации патогенных микроорганизмов.
Если даже были выявлены специфические фрагменты уреаплазмы ДНК в биологическом материале в количестве превышающем норму, паниковать не стоит. Определить, несут ли в такой концентрации патогенные микроорганизмы опасность здоровью того или иного пациента, может только высококвалифицированный специалист. Как говорилось ранее, норма у женщин и мужчин может меняться в зависимости от различных факторов.
Расшифровка при беременности
Уреаплазма при беременности на любых сроках считается в норме 10 в 4 степени. При большом показателе назначается эффективное лечение. Во время вынашивания плода при подозрении на инфекцию как правило, назначается культуральный метод диагностических мероприятий. Он дает возможность подобрать правильную схему терапии антибиотиками.
Завышение показателей может быть из-за ослабления иммунной системы беременной женщины. При вынашивании плода нахождение в мочеполовых путях патогенного организма в пределах нормы считается допустимым. В лечении в этом случае нет необходимости. При уровне концентрации болезнетворного микроба 10 в пятой степени и более врач проводит дополнительные обследования и назначает эффективные терапевтические мероприятия, которые не навредят будущей матери и ее ребенку.
Лечить патологическое состояние во время беременности необходимо в обязательном порядке. Если этого не сделать, можно инфицировать малыша и спровоцировать у него развитие следующих заболеваний:
- пневмония;
- конъюнктивит;
- пиелонефрит;
- сепсис;
- менингит и другие опасные патологические состояния.
Во время внутриутробного развития уреаплазма никак не влияет на ребенка. Инфицирование происходит во время его появления на свет по родовым путям.
Уреаплазма 10 в 4 степени, нужно ли лечить
Зачастую люди задаются вопросом, если была обнаружена уреаплазма 10 в 4 степени, нужно ли ее лечить? Ведь данный показатель стоит на грани с отклонением от нормы. Как правило, в лечении в этом случае нет необходимости. Терапевтические мероприятия, если уреаплазма имеет показатели более 10 в 4 степени назначаются в следующих случаях:
- при возникновении сильного воспалительного процесса в мочеполовых путях (при условии, что в анализах не найдены другие патогенные микроорганизмы);
- при обнаружении в биологическом материале уреаплазмы у пациентов, входящих в группу людей, которым в обязательном порядке необходимо проходить диагностические мероприятия (даже без симптоматики воспалительного процесса).
Обязательному обследованию подлежит следующая группа лиц:
- женщины, у которых было невынашивание беременности в анамнезе;
- люди с подозрением на бесплодие;
- доноры спермы.
Если пациент не входит в группу этих лиц и у него не наблюдается воспалительный процесс в мочеполовых путях, то, как правило, специалист не назначает специального лечения. Могут быть только рекомендованы меры для укрепления защитных сил иммунитета. Для этого назначаются противовирусные препараты, иммуномодуляторы, комплекс витаминов и минералов. Также, надо полноценно питаться, заниматься спортом и закаляться, отказаться от пагубных пристрастий (прием наркотических веществ, употребление спиртной продукции, курение). При сильной иммунной системе ни один патогенный микроорганизм не сможет прижиться и спровоцировать развитие серьезных заболеваний.
Методы лечения
Если патогенный микроорганизм уже однажды проник в организм, то полностью от него излечиться невозможно. Терапия направлена на предотвращение размножения и распространения уреаплазмы.
Лечение может производиться антибиотиками следующих групп:
- Тетрациклин;
- Макролиды;
- Фторхинолоны;
- Аминогликозиды;
- Левомицетин.
Дополнительно назначаются иммунотропные медикаменты. Они укрепляют защитные силы организма и тем самым уменьшают риск возникновения рецидивов.
При возникновении симптоматики уреаплазмоза необходимо незамедлительно обратиться в медицинское учреждение для диагностических мероприятий. Чем раньше будет начато лечение, тем меньше риск развития осложнений.
Терапия в домашних условиях при таком патологическом состоянии может только навредить. Поэтому самолечение недопустимо. Любые методики нетрадиционной медицины должны быть только в составе с основным лечением и в обязательном порядке согласованы с лечащим специалистом.
Видео
Как берут анализ на уреаплазму у мужчин.
Что такое уреаплазма и когда стоит сдать биоматериал на анализ
грамотрицательная палочка Ureaplasma. Передается она половым путем. Из-за своих малых размеров бактерия способна проникать даже через поры презерватива, если они больше 0,2 мкм. А также палочка передается при родах с кровью от матери к ребенку. Но для развития болезни недостаточно наличия только этого микроорганизма. Для того чтоб возникло воспаление мочевыводящих путей также необходимо наличие провоцирующих факторов. Таких, как:
- снижение иммунитета;
- наличие других инфекций мочеполовой системы;
- дисбактериоз влагалищной микрофлоры;
- беременность;
- стресс;
- длительный прием гормональных препаратов.
Данный микроорганизм является условно-патогенным, а значит, может провести внутри организма человека много лет, но так и не спровоцировать воспалительный процесс. Определить наличие палочки в вашем организме, можно только лишь сдав анализ. Обычно женщины обращаются за помощью к специалисту тогда, когда замечают симптомы воспалительного процесса, а именно:
- боль;
- слизистые выделения из влагалища;
- жжение уретры, особенно во время мочеиспускания.
Эти симптомы являются тревожным звоночком о том, что недуг вступил в стадию прогрессирования. Также берется анализ на уреаплазму у женщин уже беременных либо планирующих беременность.
Методы анализа
Диагностировать наличие уреаплазмы в организме можно с помощью лабораторного исследования. Есть несколько методов его проведения:
Метод полимеразно-цепной реакции или ПЦР
На данный момент является самым информативным методом определения наличия в организме уреаплазмы, так как он может обнаружить возбудитель даже в единственном числе. Принцип этого анализа заключается в определении уреаплазмы по ее ДНК. У пациента производится забор биоматериала, после чего исследуется в лабораторных условиях. Помимо точности, этот метод также удобен тем, что для исследования подходит любой пригодный биоматериал: влагалищные и цервикальные выделения, кровь, отделяемое из уретры.
Иммунофлюресцентный анализ или ИФА
Является он наиболее доступным методом диагностирования уреаплазмоза у пациента. Для исследования используется кровь, которую берут из вены. Далее, биоматериал изучается на наличие в нем специфических белков – антител. Иммуноглобулин вырабатывается организмом в ответ на попадание в организм чужеродных микроорганизмов. ИФА определяет наличие уреаплазмы по ДНК иммуноглобулинов. В расшифровке анализа обычно указывается положительный или отрицательный результат.
Культуральный посев
Такой метод максимально эффективен в обнаружении уреаплазмы в организме, и даже способен определить вид микроорганизма. Дело в том, что существует 16 различных видов уреаплазм, но патогенными для организма человека являются только 2 из них. Полученный биоматериал помещают в благоприятную питательную среду в термостат и, спустя трое суток, изучают выросшие там колонии микроорганизмов. Далее, колонии пересеивают в накопительную среду, где и изучают тинкториальные, антигенные и биохимические свойства уреаплазм. Это позволяет выявить чувствительность микроорганизма к тем или иным антибактериальным средствам. Расшифровка анализа имеет в себе не только положительный или отрицательный результат, но и указывает на количество микроорганизмов в биоматериале. По этим показателям можно определить является ли женщина носителем заболевания. Этот метод хоть и является самым длительным из анализов на определение уреаплазмы, но также является и самым эффективным из них.
Не стоит забывать, что независимо от результатов анализа, метод лечения уреаплазмоза может назначаться лишь вашим лечащим врачом. Чем раньше вы начнете лечение, тем быстрее и проще можно будет справиться с заболеванием.
Как сдавать биоматериал на анализ
Для корректного результата исследования необходимо придерживаться некоторых правил для подготовки к сдаче биоматериала. Рекомендуется воздержаться от:
- гигиенических процедур и спринцевания утром перед сдачей анализа;
- половых актов за несколько суток до сдачи биоматериала;
- применения местных контрацептивов за 2 суток;
- приема антибиотических и антибактериальных препаратов за неделю до анализа.
Забор биоматериала производится спустя 3 дня после менструации. А также не рекомендуется проводить анализ сразу после кольпоскопической пробы в матке.
Когда и как берется мазок на уреаплазму
Бактериологический мазок на уреаплазму берут у каждой женщины при плановом гинекологическом осмотре. Биоматериал для стандартного гинекологического анализа берется из влагалища, шейки матки, а также уретры. Пациентка может испытывать неприятные ощущения во время процедуры, но делается все очень быстро. Для снижения уровня дискомфорта рекомендуется максимально расслабить мышцы таза и делать глубокий вдох и выдох.
Полученный биоматериал наносится на предметное стекло непосредственно сразу после забора. Далее, уже в лаборатории, содержимое окрашивают специальными красителями – реагентами, причем каждый микроорганизм получает собственную окраску. Результат может быть известен спустя 3 дня. Сдача бактериоскопии назначается на период окончания менструации либо за несколько дней до ее начала.
Если же кровотечение началось раньше положенного срока, то визит к гинекологу следует отложить на период его окончания. В норме во влагалищной микрофлоре присутствует незначительное количество уреаплазмы, грибов, стрептококков и стафилококков. Также в ней содержатся и лактобациллы – полезные бактерии. Имеющиеся в расшифровке низкие показатели не являются требованием срочного медикаментозного лечения.
Посещая гинеколога хотя бы раз в полгода, вы увеличиваете шанс диагностирования уреаплазмоза на ранних стадиях.
Почему стоит внимательно отнестись к уреаплазмозу
Любое заболевание без надлежащего лечения влечет за собой массу других болезней. Из статьи вам уже стало известно, как берут анализ на уреаплазму у женщин, и что в этом нет ничего страшного или болезненного. Поэтому при первых же признаках уреаплазмоза нужно незамедлительно обратиться за помощью к специалисту.
Уреаплазма может спровоцировать развитие воспаления шейки матки, слизистой влагалища, слизистой мочеиспускательных каналов. Поднимаясь вверх по мочеполовой системе, могут также способствовать воспалению самой матки и ее придатков. Не стоит откладывать лечение на потом.